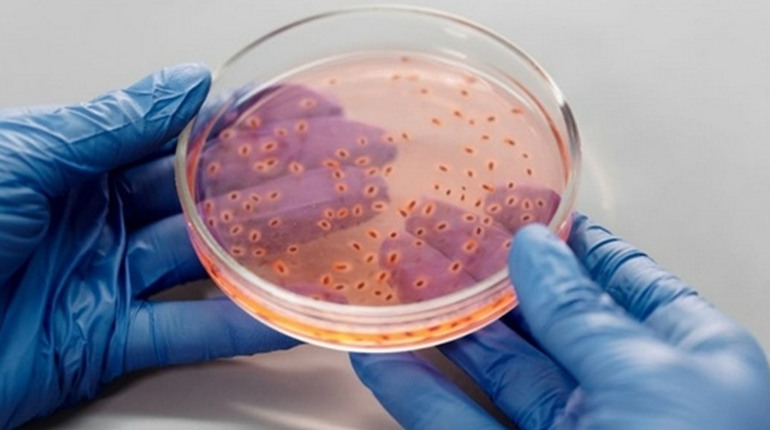
Чому кандидоз виникає: основні причини та фактори ризику

Кандидоз — одне з найпоширеніших грибкових захворювань, з яким стикаються люди незалежно від віку та статі. Збудником є дріжджоподібні гриби роду Candida, які в невеликій кількості присутні в організмі кожної людини. Проте за певних умов вони починають активно розмножуватися, спричиняючи неприємні симптоми — свербіж, печіння, характерні виділення та дискомфорт у повсякденному житті. Різні добавки https://www.repropharma.com.ua/product/reprokandyd-tm/ можуть допомогти у боротьбі з ним.
Важливо розуміти, що Candida — це умовно-патогенний мікроорганізм. Це означає, що сам по собі він не є небезпечним, але за несприятливих умов здатний спричинити серйозний дискомфорт і потребувати лікування. Саме тому знання причин виникнення кандидозу має практичну цінність для кожної людини.
Як мікрофлора пов'язана з кандидозом
Головна причина розвитку кандидозу — порушення балансу мікрофлори в організмі. У здорової людини корисні бактерії стримують ріст грибків Candida, не даючи їм розмножуватися понад норму. Коли цей баланс порушується, гриби отримують сприятливі умови для активного розмноження та поширення на слизові оболонки.
Найчастіше дисбаланс мікрофлори виникає на тлі тривалого прийому антибіотиків. Ці препарати знищують не лише шкідливі бактерії, але й корисні, що відкриває шлях для грибкової інфекції. Подібний ефект можуть мати гормональні засоби, зокрема кортикостероїди, а також деякі протизапальні препарати при тривалому використанні. Особливо уважними слід бути тим, хто регулярно приймає такі препарати через хронічні захворювання.
Варто також зазначити, що мікрофлора кишківника та піхви тісно пов'язані між собою. Порушення в одній системі нерідко відображається на стані іншої, тому підхід до профілактики кандидозу має бути комплексним і враховувати загальний стан здоров'я організму.
Фактори ризику, які варто знати
Існує низка факторів, що суттєво підвищують імовірність розвитку кандидозу. Важливо розуміти їх, щоб вчасно вжити профілактичних заходів і не допустити переходу захворювання у хронічну форму.
До основних факторів ризику належать:
- Ослаблений імунітет внаслідок хвороби, стресу або недосипання.
- Цукровий діабет, оскільки підвищений рівень глюкози створює сприятливе середовище для грибків.
- Вагітність, під час якої змінюється гормональний фон та pH слизових оболонок.
- Носіння синтетичного або занадто щільного одягу, що сприяє надмірному зволоженню та перегріву.
- Незбалансоване харчування з надмірним вмістом цукру та простих вуглеводів.
- Хронічні захворювання шлунково-кишкового тракту, що порушують склад мікрофлори кишківника.
Кожен із цих чинників може як самостійно спровокувати кандидоз, так і посилити дію інших факторів у поєднанні. Особливо небезпечним є збіг кількох факторів одночасно — наприклад, прийом антибіотиків на тлі зниженого імунітету та неправильного харчування.
Підбиваємо підсумок
Кандидоз не виникає випадково — за його появою завжди стоять конкретні причини, пов'язані зі станом імунної системи, гормональним фоном або способом життя. Розуміння цих причин — перший крок до ефективної профілактики. Якщо усунути провокуючі фактори та підтримувати баланс мікрофлори, ризик розвитку захворювання значно знижується.

Чималу роль відіграє і загальна культура ставлення до свого здоров'я. Регулярні профілактичні огляди, збалансоване харчування, помірна фізична активність і уважне ставлення до будь-яких змін у самопочутті — все це допомагає зберігати мікробний баланс в організмі та знижувати ризик грибкових інфекцій.
У разі появи симптомів кандидозу не варто відкладати консультацію з лікарем. Фахівець допоможе правильно оцінити ситуацію та підібрати відповідне лікування з урахуванням індивідуальних особливостей організму. Своєчасне звернення за медичною допомогою — найнадійніший спосіб уникнути ускладнень і повернутися до комфортного самопочуття.